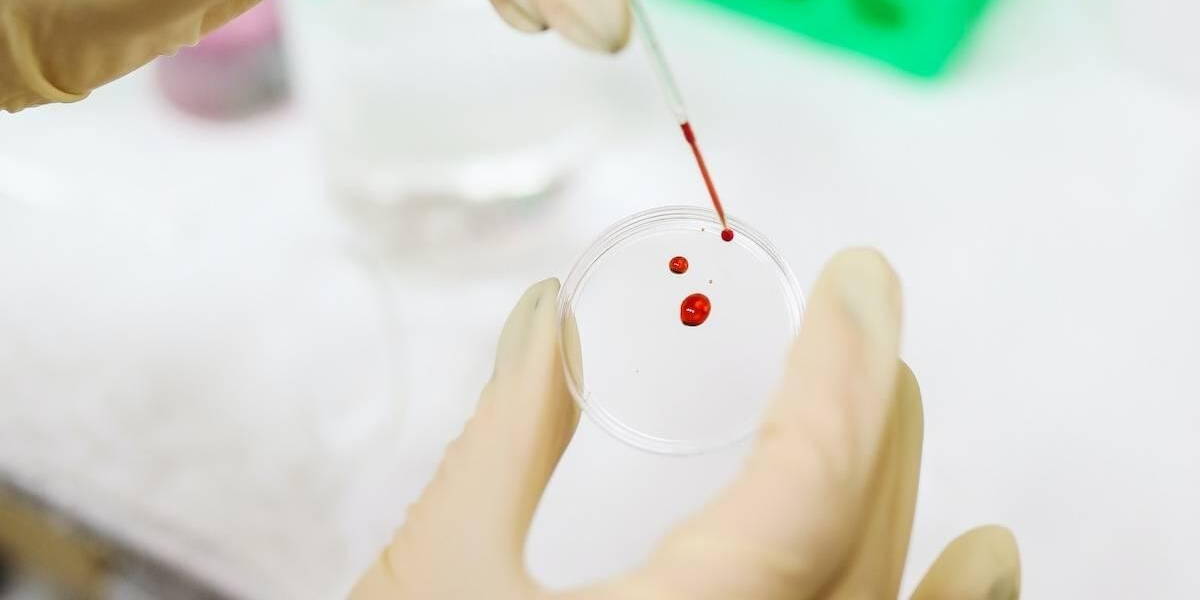
BloedOnderzoek

Binnen LabWest, het laboratorium van het HagaZiekenhuis, is een nieuwe internationale database voor hematologie en morfologie ontwikkeld. De database, CellWiki.net, bevat een groot aanbod van beeldmateriaal die, gratis, beschikbaar zijn op zowel mobiele als desktop devices. Het idee en de ontwikkeling van de database is afkomstig van klinisch chemicus in opleiding dr. Bob Smit van LabWest.
De hematologie en morfologie database van LabWest is, internationaal gezien, niet de enige database op dit gebied. Initiatiefnemer Smit zag echter dat de reeds beschikbare databases óf inhoudelijk zeer beperkt waren óf alleen na betaling toegankelijk zijn.
Voor de ontwikkeling van de database en website maakte Smit gebruik van geanonimiseerd materiaal van LabWest, het laboratorium van het HagaZiekenhuis. Met behulp van de inzet van laboratoriumprofessionals wordt ernaar gestreefd om de site en database actueel te houden.
Openbare database en naslagwerk
De nu ontwikkelde openbare website, CellWiki.net, is voor iedereen toegankelijk. Op de website staat een uitgebreide database (wiki) die toont hoe bepaalde bloedcellen en hematologische ziektebeelden zich uiten. De informatie op de website is bedoeld voor studenten, analisten en medisch specialisten (in opleiding) met interesse in de morfologie van het perifere bloed.
“Ik vind dat iedereen toegang moet hebben tot goede informatie. Betaalde toegang zorgt voor een drempel. Persoonlijk heb ik bovendien een hekel aan inloggen. Een inlogscherm past niet goed binnen mijn filosofie van laagdrempelige en snelle toegang”, aldus de klinisch chemicus en arts in opleiding tot specialist Smit.
Binnen veel ziekenhuizen zijn hematologie/morfologie onderdeel van het domein van de klinische chemie. Voor klinische chemici in opleiding, die met name aan het begin van hun opleiding overspoeld worden met vakinhoud, biedt toegang tot overzichten en naslagwerken een groot voordeel. "Als het ging om morfologie moest je toch vaak googelen of erger, een boek uit 1980 uit de kast trekken en maar hopen op foto’s van 1 of 2 cellen die een beetje lijken op wat je zocht", aldus Smit.